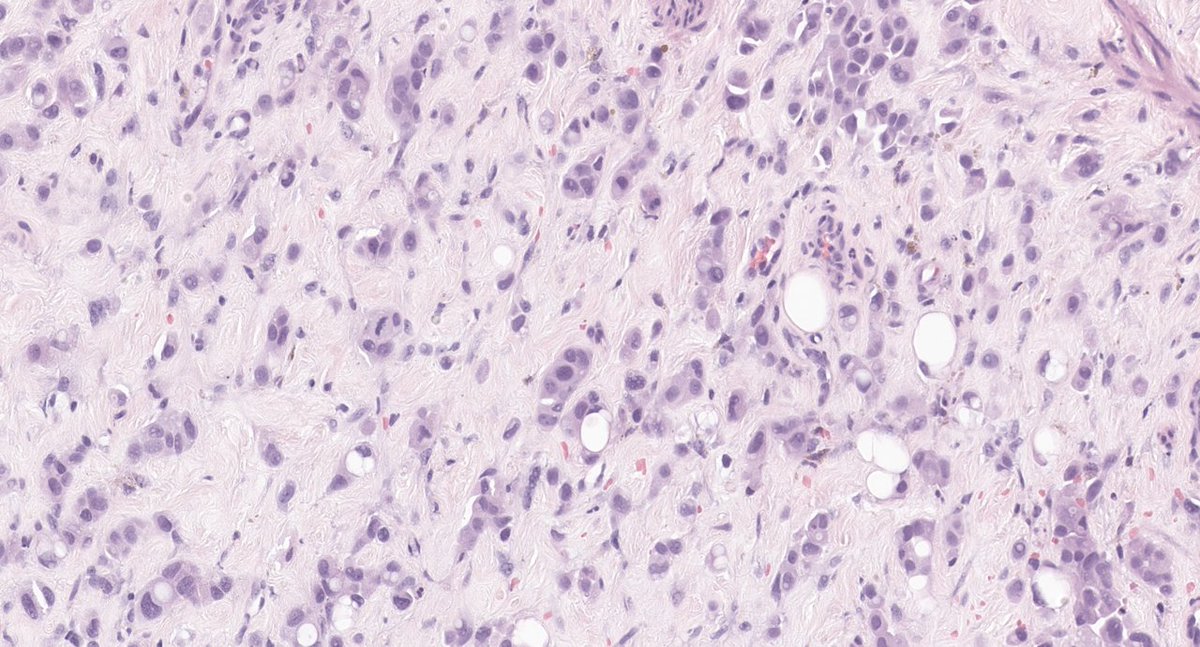
Mariya Kuk 🇺🇦 tweet media
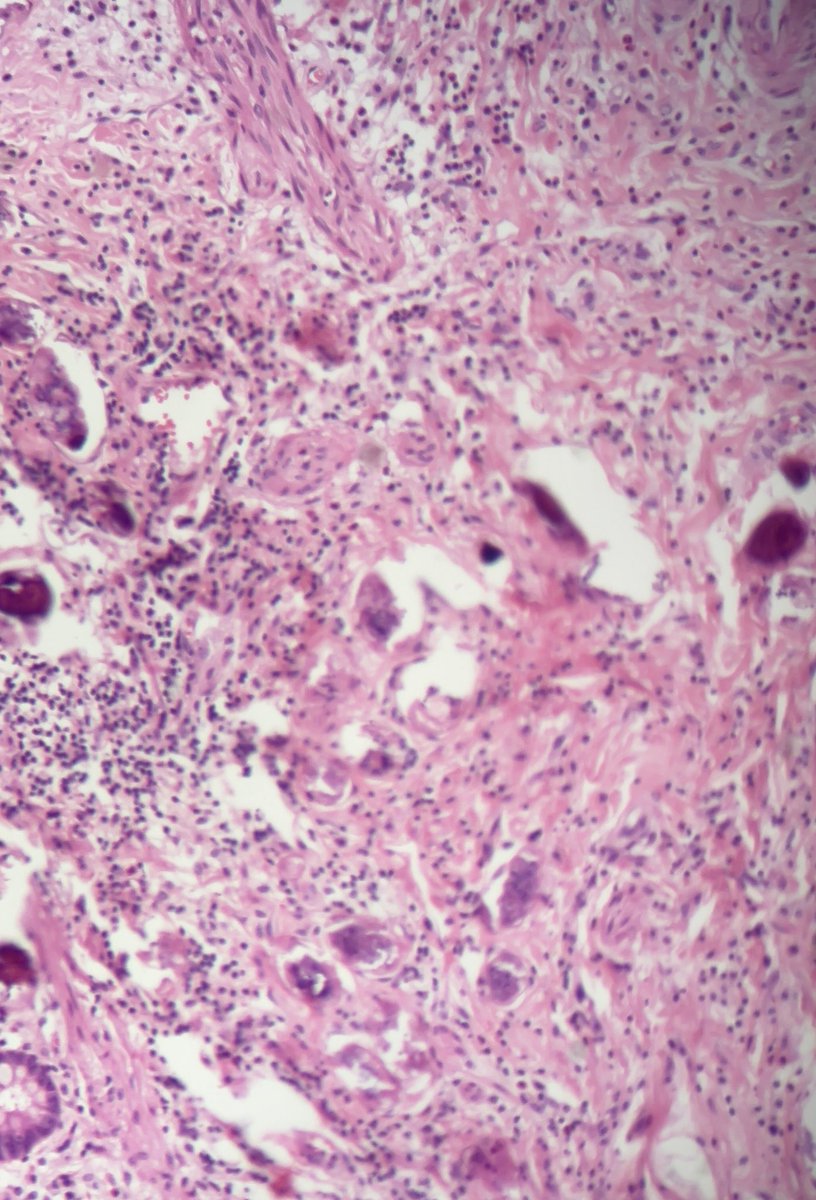
Ali Alzughbi tweet media

Mahabub Alam
19 posts

Mahabub Alam
@docrobin52
Assistant Professor, Pathology.
Dhaka, Bangladesh Katılım Ocak 2015
122 Takip Edilen17 Takipçiler

@aneezairfan01 A recorded version would be greatly appreciated. Thank you!"
English

Please join us for our lymphoma unknown conference at 4:00pm CST on 7/25/2025 with Jahg Wong, MD / L. JEFFREY MEDEIROS, MD
Zoom link:
mdacc.zoom.us/j/93148067170?…
Passcode: 127876
Slides:
pathpresenter.net/public/present…
Case histories:

English

👉 70 YO female presenting with abdominal mass. Colonoscopy showed two large sigmoid masses.
What is your diagnosis?
Any further work-up/IHC?
#PathTwitter #GIpath #Surgpath #Pathology #Pathresidents




English

@VickeryJasmine Mammary carcinoma with osteoclast like giant cells
English

Solitary breast mass in a 65 year old female, let me know your thoughts before I give the diagnosis :) #breastpath #pathtwitter #pathx #pathology #pathresidents




English

@RenalPathLabs @Renalpathsoc Don’t see kidney biopsy, but I’ll try. Silver stain showing vasculitis of a medium sized artery, granular casts and dense interstitial inflammation. 🤔
English

Images say it all. The disease,the process,possible culprit, the misery of that organ system & about the nicely done stain..Residents,want to describe this pic?Native Bx
#PathoResidents #NephrologyResidents #PathTwitter #Nephtwitter #AskRenal #RenalPathLabsGurugram @Renalpathsoc


English

Brochial biopsy of a 65 yrs old lady.
CT chest: extensive bilateral ground glass crazy paving with consolidation.
Is this AAH/AIS/ lepidic adeno?
#PathTwitter #pathx #pathology #lungpath #lung




English

38 yrs, cervix broad and congested.
I’m thinking of atypical endocervical cells. Your opinion please.
#PathTwitter #Cytopath #Gynpath #Paps




English